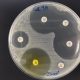

Marilourdes de Torres: «Los menús de hospital son una combinación entre ciencia e imaginación»

Simulan el comportamiento de una minicélula viva en 3D
1 febrero, 2022
Resistencia bacteriana a los antibióticos, la epidemia silenciosa
1 febrero, 2022Responsable de la puesta en marcha de la Unidad de Nutrición del Hospital Miguel Servet, la enfermera es una de las grandes pioneras en la alimentación a los pacientes en la Comunidad.
Marilourdes de Torres es una de las grandes pioneras de la alimentación en el ámbito sanitario aragonés. Entre sus logros, destaca la puesta en marcha de la Unidad de Nutrición del Hospital Miguel Servet. Además de poseer una experiencia dilatada en este campo, es delegada de Nutrición del Consejo General de Enfermería de España y coordinadora de Nutrición del Colegio de Enfermeras de Zaragoza.
¿Cuál es el proceso que se sigue para conformar los menús de un hospital?
Es una especie de combinación de la ciencia con la imaginación para conseguir hacer unas dietas variadas en consonancia con las necesidades de la población diana, que son las personas ingresadas. Por tanto, hay que calibrar las dietas con las calorías necesarias, añadir alimentos que deban ser mayoritarios y restringir los que no estén permitidos por las características de la patología a la que se van a aplicar. Las dietas se clasifican por números añadiendo al lado el nombre de la patología o circunstancia digestiva para la que está diseñada.
La alimentación de los pacientes era la adecuada, pero la ciencia de la nutrición no estaba tan avanzada, por lo que el número de dietas era menor y los menús menos variados. Fue una de las primeras acciones que, de acuerdo con el jefe de cocina, decidimos poner en marcha.
¿Cómo fue el proceso de creación de la unidad?
Lo más apasionante es que partíamos de cero. Comenzamos por elaborar un código de dietas y, como entonces no había ningún programa mágico, el cálculo de calorías por ingesta de cada menú lo hacía como el resto de enfermeras de las otras unidades de España, con papel cuadriculado, lápices, goma de borrar y sacapuntas. Quedaron tan bien las dietas que hicimos una presentación oficial en el Insalud. Todo ello a la vez que ya se iba incrementando la nutrición enteral por sonda, así que me convertí en una supervisora educadora con mis colegas de planta y llorona con mi directora, el gerente y la adjunta de recursos humanos para conseguir una mayor dotación de recursos –aumento de plantilla, nutribombas, tipos de sonda…– Y, para todo eso, había que dar seminarios y cursos de formación continuada en nutrición y dietética, que organicé junto a la responsable de docencia y que tuvieron un gran éxito.
¿Cómo ha cambiado la alimentación del paciente en estos años?
Las dietas basales han ido adaptándose a cómo hemos cambiado los gustos. El servicio de Hostelería ha ido adquiriendo mejor tecnología en electrodomésticos y se puede elaborar una alimentación más segura y saludable. Y, por supuesto, teniendo muy en cuenta las mejoras en sostenibilidad, como las cámaras de conservación, los enormes recipientes de cocina y la gestión de residuos. A esto también ayudan los avances de la ciencia de la nutrición y la tecnología alimentaria.
Según lo que ha vivido en su carrera, ¿cómo se ejemplifica lo que contribuye la nutrición a la mejora de los pacientes?
Cuando el organismo recibe todos los nutrientes, funciona bien. Si los recibe en exceso, se refleja en alteraciones de la analítica. Y, si son insuficientes, se genera desnutrición. Evitar que un paciente se desnutra es lo que más se debe controlar durante el ingreso. La enfermera, ante la sospecha de riesgo, debe hacer un cribado nutricional, que ya está protocolizado en todos los hospitales. Entonces, a ese paciente se le hace un seguimiento y se fortifica su alimentación desde cocina según pautas de la Unidad de Nutrición y Dietética o con suplementos de farmacia. Se le controla y, si la desnutrición no revierte, se comienza con la nutrición enteral, que se administra a través de una sonda que suele entrar por la nariz y llega al estómago.
¿La mayor concienciación sobre alimentación que experimenta la sociedad ha tenido efecto a nivel sanitario?
Se habla mucho de dieta sana, pero cada vez empeoran más los hábitos alimentarios. Como enfermera que lleva toda su vida profesional haciendo educación nutricional con usuarios y pacientes, creo que no tenemos que bajar la guardia y que hay que seguir hablando con entidades como asociaciones de vecinos o de consumidores. La alimentación perfecta, según la OMS, la FAO y la ONU, es la dieta mediterránea, y aquí la tenemos en la puerta de casa con la huerta del Ebro y sus ricas hortalizas, o la del Jalón con sus frutas jugosas.
Fuente: Heraldo de Aragón




